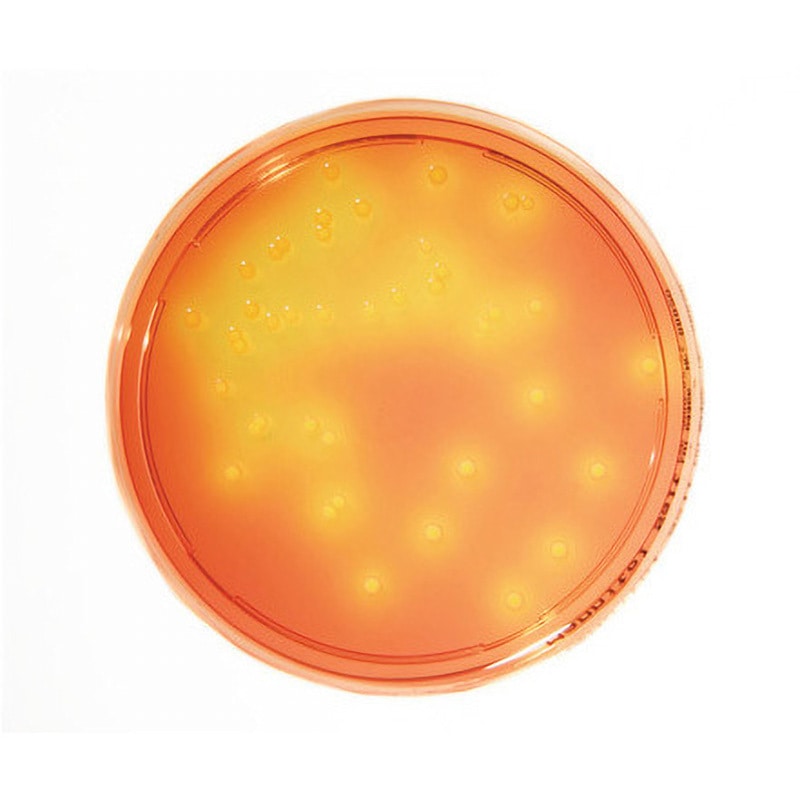
1.46023.0020 特定微生物試験培地 1箱(20枚) Merck(メルクミリポア) 【通販モノタロウ】

新入荷再入荷
1.46684.0020 TSA+LT 90mm-ICR+ 146684 20PACK 1セット(20個) Merck(メルクミリポア) 【通販モノタロウ】 バイオ・食品(菌)関連用品
 タイムセール
タイムセール
終了まで
00
00
00
999円以上お買上げで送料無料(※)
999円以上お買上げで代引き手数料無料
999円以上お買上げで代引き手数料無料
通販と店舗では販売価格や税表示が異なる場合がございます。また店頭ではすでに品切れの場合もございます。予めご了承ください。
商品詳細情報
| 管理番号 |
新品 :3855_1958_1 中古 :3855_1958_11 |
メーカー | バイオ・食品(菌)関連用品 | 発売日 | 2026-01-11 | 定価 | 8,263円 | ||
|---|---|---|---|---|---|---|---|---|---|
| 原型 | バイオ・食品(菌)関連用品 | ||||||||
| カテゴリ | |||||||||